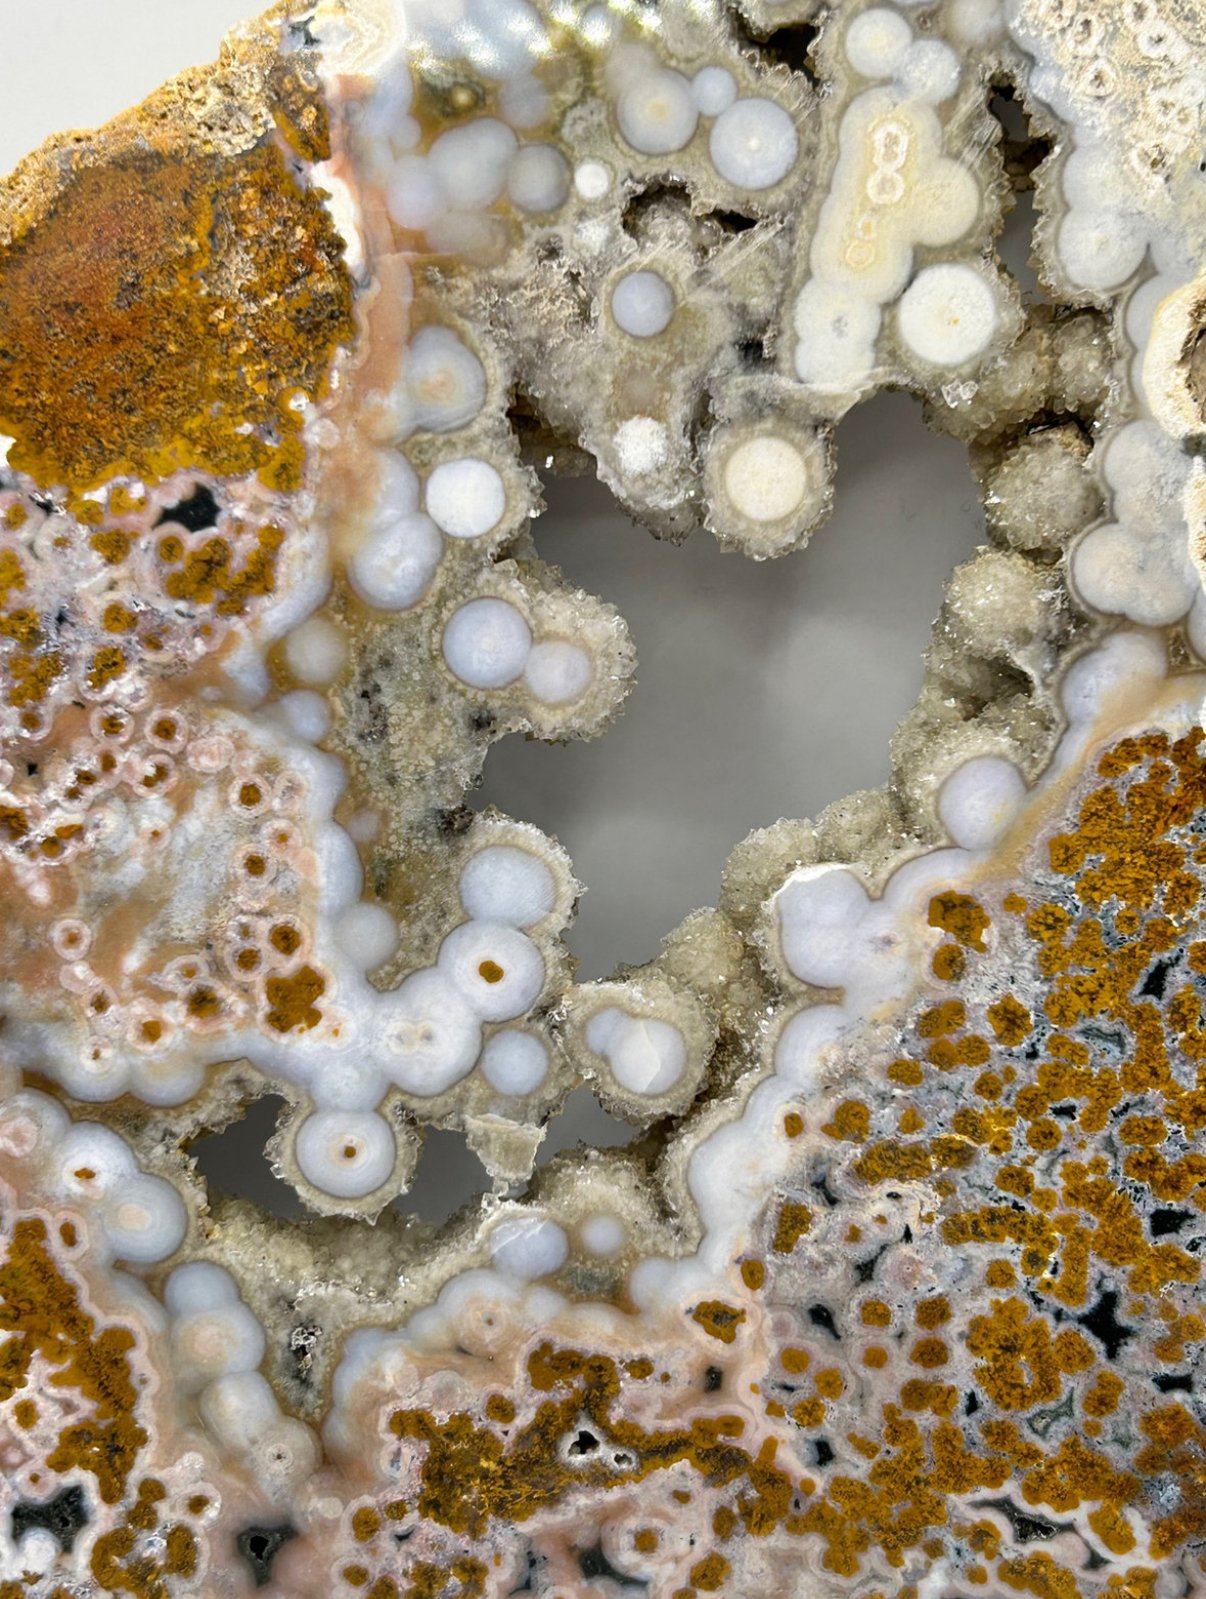
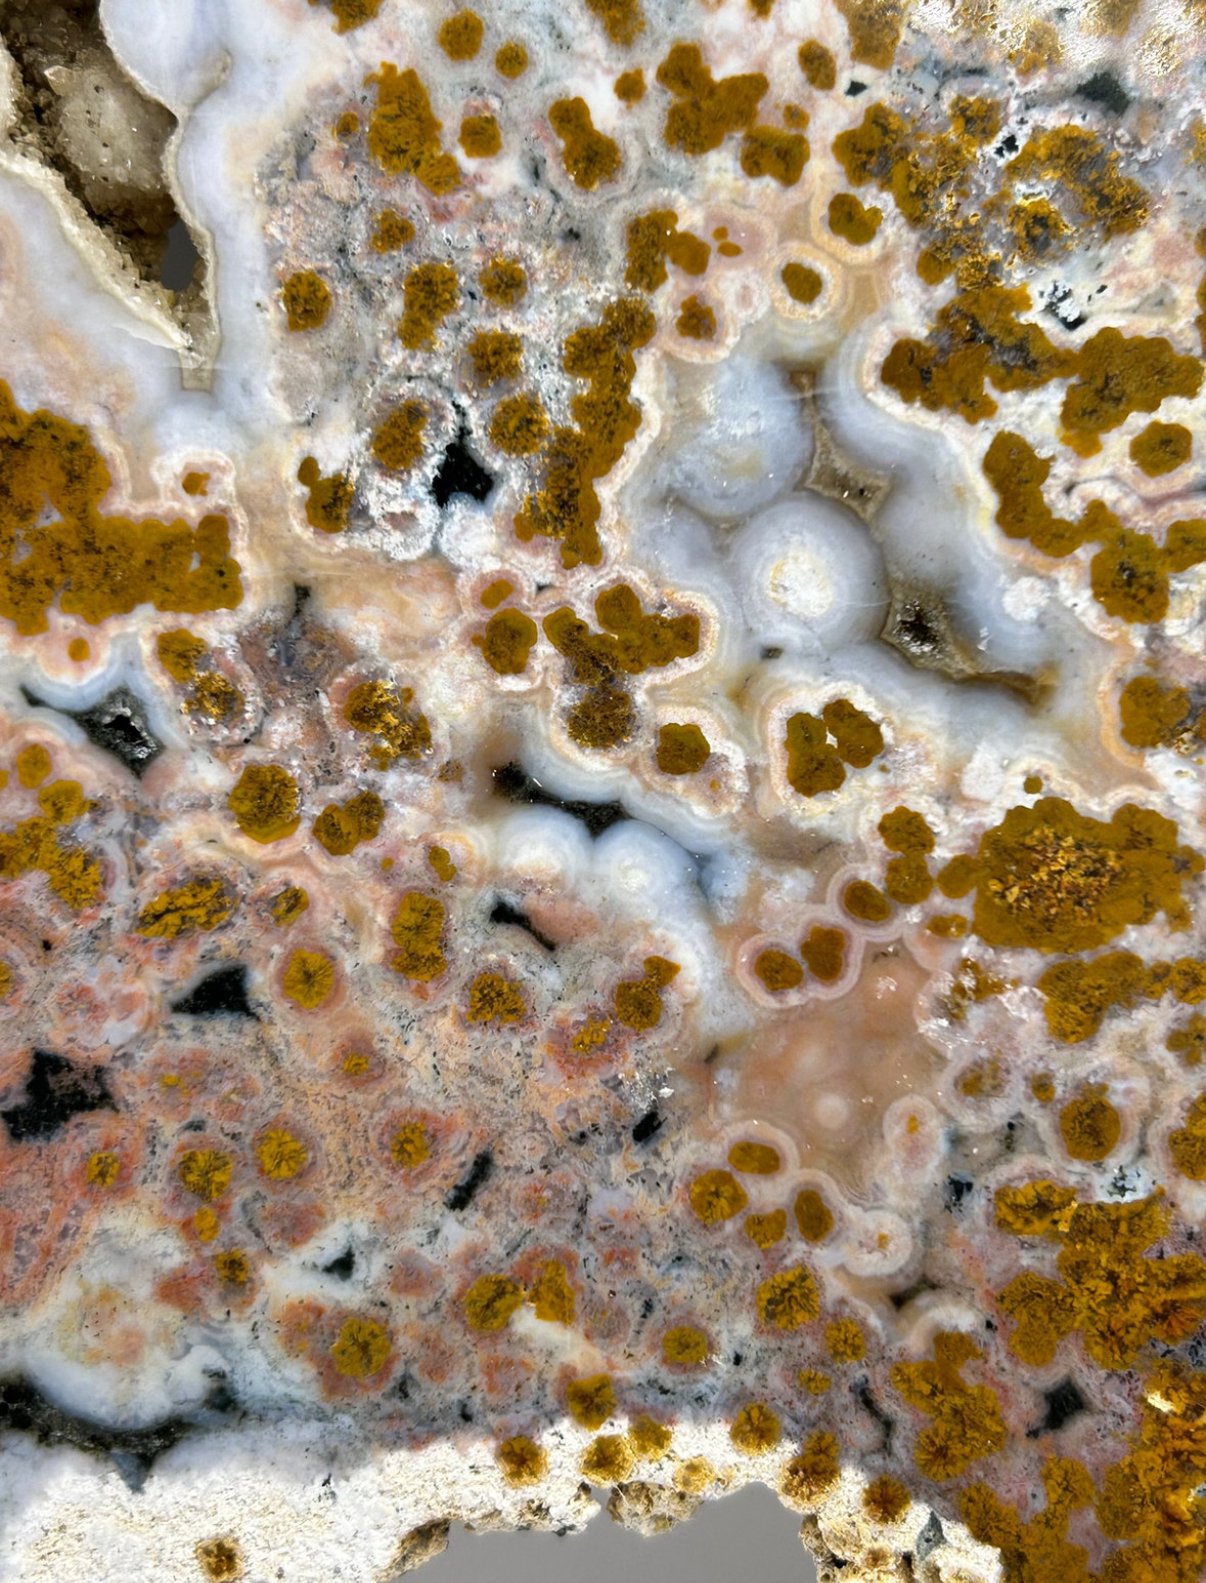

I’ve held on to this beauty for long enough, it’s time it found its forever home.
This is a genuine Ocean jasper from the mined out 8th vein pocket in Marovato, Madagascar. An extremely rare and sought after material.
Weighs 824grams
Measures 300mm by 195mm (widest points)
Ocean jasper is from Madagascar and the 8th vein is one of the recent finds. This vein is now mined out.
Ocean Jasper is a unique stone that carries the healing energy of the ocean. It releases suppressed emotions, bringing them to the surface to allow for transformation and healing. It opens and heals the heart chakra, and reminds one to be accepting of the cycles of life. It helps one look to the future with hope, making it beneficial for anyone suffering with depression, heartache, grief, or emotional trauma.
Element: Earth
Chakras: Throat, Heart, Solar Plexus